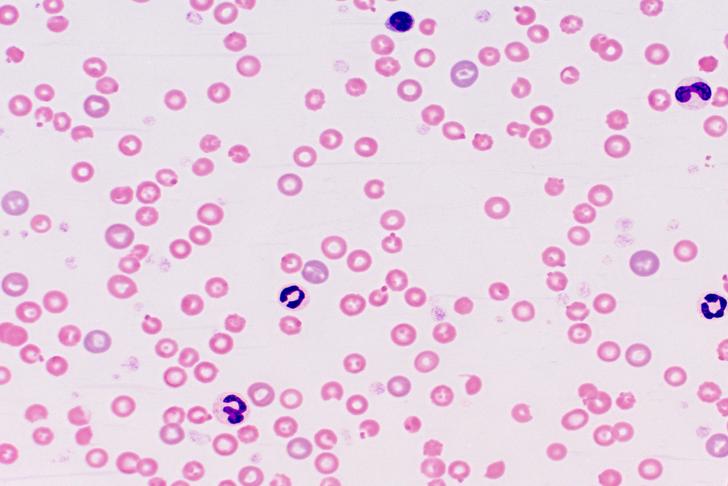
hemolytic anemia

10 Causes of Anemia: Understanding the Underlying Factors
Anemia is a common blood disorder characterized by a decrease in the number of red blood cells or a lack of hemoglobin in the blood. This can lead to a reduced ability of the blood to carry oxygen, resulting in fatigue, weakness, and shortness of breath. There are several underlying causes of anemia, and understanding these factors can help in the prevention and treatment of the condition. In this article, we will explore 10 common causes of anemia.
Iron-Deficiency Anemia
Iron-deficiency anemia is the most common type of anemia and occurs when the body lacks sufficient iron to produce hemoglobin[[2]]. This can be caused by blood loss, poor iron absorption, or inadequate iron intake. Iron supplements and dietary changes can help treat this form of anemia.

Advertisement
Vitamin Deficiency Anemia
Vitamin deficiency anemia occurs when the body lacks essential vitamins, such as vitamin B12 and folic acid, needed for the production of red blood cells[[3]]. This can be due to poor dietary intake, malabsorption, or certain medications. Treatment may involve vitamin supplements or dietary changes.

Advertisement
Hemolytic Anemia
Hemolytic anemia is a condition in which red blood cells are destroyed faster than the body can produce them[[4]]. This can be caused by inherited conditions, autoimmune disorders, infections, or certain medications. Treatment depends on the underlying cause and may include medications, blood transfusions, or surgery.
Advertisement
Aplastic Anemia
Aplastic anemia is a rare but serious condition in which the bone marrow fails to produce enough red blood cells, white blood cells, and platelets[[5]]. This can be caused by radiation, chemotherapy, certain medications, or autoimmune diseases. Treatment may involve blood transfusions, medications, or bone marrow transplantation.

Advertisement
Sickle Cell Anemia
Sickle cell anemia is an inherited blood disorder in which red blood cells become misshapen and break down more rapidly than normal cells[[6]]. This can lead to a shortage of red blood cells and cause complications such as pain, infections, and organ damage. Treatment may include medications, blood transfusions, and bone marrow transplantation.

Advertisement
Anemia of Chronic Disease
Anemia of chronic disease is a type of anemia that occurs in people with long-term medical conditions, such as cancer, infections, or autoimmune diseases[[7]]. This form of anemia is usually mild and may improve with treatment of the underlying condition.

Advertisement
Anemia and Kidney Disease
Anemia is a common complication of chronic kidney disease, as the kidneys produce a hormone called erythropoietin, which stimulates the production of red blood cells[[8]]. When the kidneys are damaged, they may not produce enough erythropoietin, leading to anemia. Treatment may involve medications or blood transfusions.

Advertisement
Anemia in Pregnancy
Anemia is common during pregnancy, as the body needs more iron to support the growth of the fetus and the expansion of the mother’s blood volume[[9]]. Pregnant women may need to take iron supplements to prevent or treat anemia.

Advertisement
Lead Poisoning
Lead poisoning can cause anemia by interfering with the body’s ability to produce hemoglobin[[10]]. This can occur through exposure to lead in paint, dust, soil, or water. Treatment for lead poisoning may involve medications to remove the lead from the body and prevent further damage.

Advertisement
Symptoms of Anemia
Below are some common symptoms of anemia:
Common symptoms of anemia include:
Fatigue or weakness
Pale or yellowish skin
Irregular heartbeats or palpitations
Shortness of breath
Dizziness or lightheadedness
Chest pain
Cold hands and feet
Headache
Brittle nails
Unusual cravings for non-nutritive substances, such as ice, dirt, or starch (known as pica) Restless legs syndrome
Some forms of anemia are mild and temporary, while others can be long-term and potentially serious.
Advertisement
Treatmends for Anemia
Treatment for anemia depends on the type, cause, and severity of the condition. Some types of anemia are temporary and require no specific treatment, while others might require ongoing treatment. Here are some possible treatments:
Dietary changes and supplements: If your anemia is caused by a deficiency in iron, vitamin B12, folic acid, or other nutrients, your doctor may recommend changes to your diet or nutritional supplements.
Medications: Various medications can be used to increase the production of red blood cells in your body or to treat an underlying cause of anemia. For example, if your anemia is due to an autoimmune attack on red blood cells, your doctor may prescribe drugs to suppress your immune system.
Iron infusion or injections: If you have severe iron deficiency anemia, oral iron supplements might not be sufficient, and it might be necessary to administer iron intravenously or through injections.
Blood transfusions: In severe cases, or if the anemia is causing significant symptoms, a transfusion of red blood cells can be performed.
Surgery: If anemia is caused by an ulcer or tumor in your body that’s bleeding, you might need surgery to control the bleeding.
Bone marrow transplantation: A bone marrow or stem cell transplant might be considered in cases of severe, life-threatening forms of anemia (such as aplastic anemia or certain inherited anemias).
Advertisement
Conclusion
In conclusion, anemia, with its diverse causes and manifestations, underscores the importance of understanding our body’s signals and reacting proactively. Whether the condition stems from dietary deficiencies or underlying chronic diseases, recognizing its tell-tale signs—such as fatigue, pallor, and palpitations—is crucial for prompt management.
The spectrum of anemia can span from benign, short-term conditions to chronic, potentially life-threatening ones. This wide range highlights the necessity for professional medical evaluation if symptoms persist. Ensuring a correct diagnosis is crucial as the treatment strategies for anemia are intrinsically linked to its underlying cause and type.
Potential treatment avenues can vary widely, encompassing dietary adjustments and supplementation to more intensive approaches like medications. In severe instances, interventions such as blood transfusions or even bone marrow transplants may be required. Prior to embarking on any treatment course, a comprehensive discussion with your healthcare provider is imperative to develop a treatment plan that’s optimized to your unique form of anemia and overall health status.
To sum up, dealing with anemia effectively hinges on proactive healthcare engagement, immediate consultation with healthcare professionals upon noticing symptoms, and faithful adherence to the prescribed treatment regimen. Embracing these measures can greatly aid in managing anemia, contributing to enhanced health, vitality, and quality of life.

Advertisement